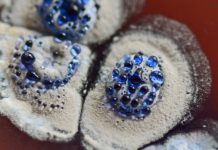

Últimas Notícias
ARTIGOS CIENTÍFICOS
- All
- Artigos Científicos
- Atualidades
- Biologia
- Biomedicina
- Cameraprive Live
- Cursos
- Enfermagem
- Entrevistas
- Especiais e Entrevistas
- Farmácia
- Fisioterapia
- Gadgets
- mail order wives
- Marketing e Saúde
- Medicina
- Nutrição
- O Especialista Responde
- Odontologia
- Oncologia
- Pesquisa
- podcast
- Psicologia
- Psiquiatria
- Saúde da Criança
- Saúde da Mulher
- Saúde do Idoso
- Saúde e bem estar
- Saúde e o Direito
- sienews
- Tecnologia
- Viagem e Saúde
- Vídeos
Mais
O médico tem o dever de requerer todo o exame existente...
É uma pergunta importante que diversos pacientes têm dificuldade de compreender e que envolve a relação entre benefício e malefício, pois, por...
SIE ENTREVISTAS
SAÚDE E BEM ESTAR
- All
- Artigos Científicos
- Atualidades
- Biologia
- Biomedicina
- Cameraprive Live
- Cursos
- Enfermagem
- Entrevistas
- Especiais e Entrevistas
- Farmácia
- Fisioterapia
- Gadgets
- mail order wives
- Marketing e Saúde
- Medicina
- Nutrição
- O Especialista Responde
- Odontologia
- Oncologia
- Pesquisa
- podcast
- Psicologia
- Psiquiatria
- Saúde da Criança
- Saúde da Mulher
- Saúde do Idoso
- Saúde e bem estar
- Saúde e o Direito
- sienews
- Tecnologia
- Viagem e Saúde
- Vídeos
Mais
MEDICINA MODERNA
O ESPECIALISTA RESPONDE
O tipo sanguíneo está associado ao risco de COVID19?
Um novo estudo preliminar encontrou correlações entre o tipo sanguíneo e a probabilidade de ser hospitalizado com o COVID-19. Segundo os autores,...